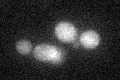
YIL021W
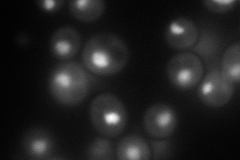
YIL021W
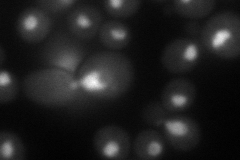
YIL021W
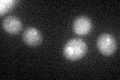
YIL021W

View description
RNA polymerase II third largest subunit B44, part of central core; similar to prokaryotic alpha subunit
Localization:
Intensity:
Fold change:
Significance:
-
C’ GFP library in SD
cytosol19.09 -
N' NOP1pr-GFP in SD
nucleus121.483 -
N' TEF2pr-mCherry in SD
nucleus88.9205 -
N' NATIVEpr-GFP in SD

nucleus90.7854 -
N' TEF2pr-VC and Cyto-VN in SD

nucleus45.5199 -
C’ GFP library in SD+DTT
cytosol18.090.94No -
C’ GFP library in SD+H2O2

cytosol17.090.89No -
C’ GFP library in Starvation Media

cytosol16.670.87No -
C’ GFP library on the background of Pup2-DaMP

cytosol -
C’ GFP library on the background of CCT mutant

cytosol19.36971.01423No
